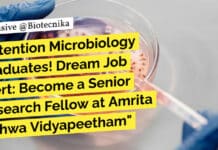
Attention Microbiology Graduates! Amrita Vishwa Vidyapeetham Hiring MSc For SRF Role "Attention Microbiology Graduates! Dream Job Alert: Become a Senior Research Fellow at Amrita Vishwa Vidyapeetham"

Govt Chittaranjan National Cancer Institute MSc Medical Microbiology SRF Recruitment!
Govt CNCI MSc Job For Microbiology
Chittaranjan National Cancer Institute
(An Autonomous Institute under Ministry of Health and Family Welfare, Govt. of India)
2nd Campus - Street...
DBT Call for Applications for Ramalingaswami Re-Entry Fellowship Programme 2023-24
Ramalingaswami Re-Entry Fellowship Programme 2023-24, Apply Online
Deadline extended to 29th February 2024 (11:59 PM IST)
Department of Biotechnology
Ministry of Science and Technology
Government of India
Call...
Attention Microbiology Graduates! Amrita Vishwa Vidyapeetham Hiring MSc For SRF Role
Amrita Vishwa Vidyapeetham Hiring! MSc Microbiology Apply For SRF Role!
Amrita Vishwa Vidyapeetham is a multi-disciplinary, research-intensive, private university, educating a vibrant student population of...
Dream Job Alert: Bioinformatics, Biotech, Biochem Project Assistant Opening at NIAB – Apply Online...
NIAB Bioinformatics Project Job - Biotech, Biochem, Immunology & Microbiology Apply
Applications are invited from suitable candidates for filling up the following position at National Institute...
Biotech Job at IIT – Apply For JRF Post at IIT Hyderabad!
IIT Hyderabad Biotechnology JRF Vacancy - Apply Now!
Subject: Advertisement for the post of Junior Research Fellow (No. of Post: One)
Applications are invited from Indian...
Attention Biology Enthusiasts! Novartis is Hiring Expert Curators to Revolutionize Drug Discovery – Apply...
Novartis Biology Curation Expert Recruitment, Apply Online
Role Title: Curation Expert
Location: Hyderabad
About the Role:
Novartis Institutes for BioMedical Research (NIBR) is the global pharmaceutical research organization...
Revolutionize Food Quality with iD Fresh’s Expert Quality Head
iD Fresh Quality Head Job For Food Science, Food Tech - Apply Now
Quality Head
About iD Fresh Food
iD Fresh Food’s mission is to make...
Dr Reddy’s Institute Seeks Applicants for Groundbreaking Drug Research Project – Apply Now for...
Dr Reddy's Institute Biological Sciences Project Job - Applications Invited
A D V E R T I S E M E N T
Recruitment of a...
Breaking News: High-Paying Job Opportunity in Biotechnology Project at INST Mohali! Apply Now and...
INST Mohali Biotechnology Project Job - Attend Walk-In
INSTITUTE OF NANO SCIENCE AND TECHN0LOGY
(An Autonomous Institute of Department of Science and Technology,
Government of India)
Knowledge City,...
Get Paid to Research Zoology at Sikkim University! Don’t Miss Out on this Exciting...
Sikkim University Zoology Research Fellow Recruitment
SIKKIM UNIVERSITY
(A central university established by an Act of Parliament of India in 2007 and accredited by NAAC in...
Calling all Life Science and Genetics Enthusiasts! Join Our Team as a Clinical Project...
Neuberg Diagnostics Jobs - Life Sciences & Genetics Apply
CENTER FOR Neuberg DIAGNOSTICS GENOMIC MEDICINE
Thank you for considering a career with Neuberg Diagnostics Genomic Medicine....
Looking for Bioinformatics Jobs? Apply Now for Exciting Project Positions at NIBMG!
NIBMG Bioinformatics Jobs - Life Sciences Apply For Project Posts
NATIONAL INSTITUTE OF BIOMEDICAL GENOMICS
(An Autonomous Institution of the Government of India)
P.O.: N.S.S, Kalyani 741251,...
Get Paid to Research Rare Genetic Disorders! Apply Now for a Project Associate Job...
CDFD Hiring! Apply For Project Associate Job
CENTRE FOR DNA FINGERPRINTING AND DIAGNOSTICS
INNER RING ROAD, UPPAL,
HYDERABAD – 500 039
Ph: +91-40-27216015
www.cdfd.org.in
Advt. No. CDFD/EMPC/03/DEC’23
CDFD, an autonomous Institute...
Exciting Job Opportunity in Bioinformatics Research at VIT Vellore – Apply Now!
VIT Vellore Bioinformatics Research Job - Apply Online
Junior Research Fellow (JRF) - VIT Vellore
Applications are invited for the Post of Junior Research Fellow (JRF)...
Want to Work on Groundbreaking HIV Research? NII Delhi is Hiring! Don’t Miss this...
NII Delhi Walk-In-Interview For Life Sciences - Project Job Available
NATIONAL INSTITUTE OF IMMUNOLOGY
ARUNA ASAF ALI MARG
NEW DELHI
ADVERTISEMENT FOR WALK-IN-INTERVIEW
Name of the Position: Project Assistant
Duration:...